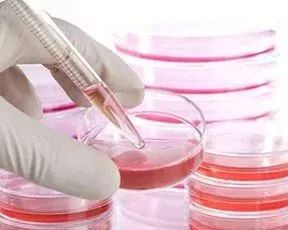

- 脐带血只能救孩子?四年前的脐血治疗成人白血病
- 来源: 中华网 时间:2018-04-19
家住安徽省的魏先生是个厨师,有两个年幼的女儿。一家人原本过着很平静的生活,但是不幸却悄悄地降临。
2016年,魏先生觉得有些腹痛,就去县人民医院做了血常规,查出来白细胞高达267,B超显示巨脾。最终被确诊为慢性粒细胞白血病。
慢性粒细胞白血病是一种影响血液及骨髓的恶性肿瘤,全球发病率约1/10万,占全部白血病的20%左右。
在我国发病率约0.36/10万,占白血病的第三位。由于慢性粒细胞白血病进展比较缓慢,所以很多病人没有明显的早期症状。
这个疾病的特点是产生大量不成熟的白细胞,这些白细胞在骨髓内聚集,抑制骨髓正常造血,并且会通过血液在全身扩散。
一听到“白血病”这三个字,一家人就觉得天都要塌下来了。
魏先生经过了数次化疗,身体状况仍然不见好转。可是他上有七十多岁的父母,下有两个可爱的女儿,作为家里的顶梁柱,不能就此倒下!
最后,魏先生辗转来到安徽省立医院,医院的专家孙自敏教授建议:做造血干细胞移植才能根治魏先生的白血病。
经过配型查询,魏先生在北京市脐血库幸运地找到了一份配型成功的脐带血。脐血复苏后细胞活性达到了98.41%,细胞数量达到35.21*10^8。
根据我国卫计委颁发的《造血干细胞移植技术管理规范(2017年版)》规定:患者使用脐带血移植的标准为大于2*10^7/公斤。也就是说,仅这份脐带血,就足以救治一个体重超过300斤的患者。魏先生的体重是156斤,医生随即决定用这份脐血进行造血干细胞移植。
魏先生的移植手术已于3月22日进行,一袋宝贵的新生儿脐带血,让这个原本陷入绝望的男人,重新收获了生的希望。
相关知识
1、骨髓、外周血、脐带血是造血干细胞的三大主要来源。
2、非亲缘骨髓及外周血需要通过供者捐赠,非亲缘间配型相合的几率只有十万分之一。
3、脐带血造血干细胞具有采集方便;对被采集者无伤害;实物储存,临床应用及时;移植后排斥率低且程度较轻等优势。
4、储存脐血自用,不存在配型问题;孩子的脐带血与父母是半相合;脐带血在非孪生兄弟姐妹间的配型全相合率是25%;储存脐带血可增加家庭成员找到合适造血干细胞来源的几率。


